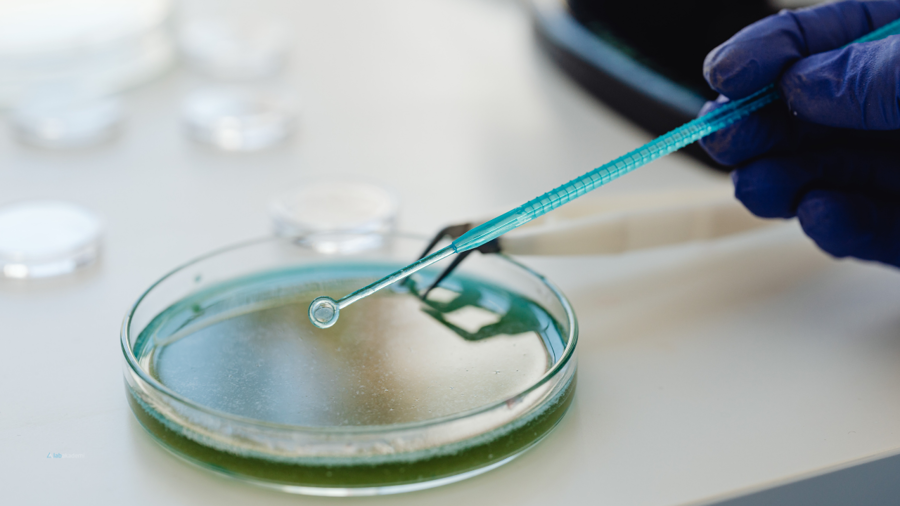
Kozmetik Mikrobiyolojisinde Mantar Kontaminasyonu: ISO 16212 Standartı ve Analiz Teknikleri

Kozmetik ürünlerin formülasyonunda kullanılan su ve organik bileşenler, sadece bakteriler için değil, aynı zamanda maya ve küfler için de uygun üreme ortamları oluşturur. Mantar kontaminasyonu genellikle ürünün renginde, kokusunda ve dokusunda istenmeyen değişimlere yol açarak ürünün ticari değerini yok eder. ISO 16212 (Kozmetikler - Mikrobiyoloji - Maya ve küf sayımı) standardı, bu organizmaların tespiti ve sayımı için geliştirilmiş uluslararası geçerli protokoldür.
ISO 16212 Standartı Nedir ve Ne Amaçla Kullanılır?
ISO 16212, kozmetik ürünlerde bulunan maya ve küflerin aerobik koşullarda, seçici besiyerleri kullanılarak sayılması (kantitatif analiz) için kullanılan bir standarttır.
Akademik çerçevede bu standart, mantarların bakterilere göre daha yavaş büyüme hızı ve farklı çevresel gereksinimlerini dikkate alarak özelleşmiş bir metodoloji sunar. Amacı, ürünün mantar yükünün yasal limitler (genellikle 100 veya 1000 kob/g-mL) içerisinde olup olmadığını bilimsel olarak kanıtlamaktır.
ISO 16212 Standartının İçeriği Nelerdir?
Bu standart, mantarların izolasyonu ve sayımı için kritik adımları içerir:
Seçici Besiyeri Kullanımı: Bakterilerin büyümesini baskılayan ve mantarların gelişimini destekleyen SDA (Sabouraud Dextrose Agar) veya DRBC gibi besiyerlerinin kullanımı.
Analitik Yöntemler: Numunenin seyreltilmesi, dökme plaka veya yayma plaka teknikleri ile ekimin yapılması.
İnkübasyon Parametreleri: Mantarların büyümesi için genellikle 25°C - 28°C gibi daha düşük sıcaklıklarda, 5 güne (120 saat) kadar sürebilen uzun süreli inkübasyon süreçleri.
Morfolojik Ayrım: Plaka üzerinde gelişen kolonilerin maya (pürüzsüz, kremsi) veya küf (pamuksu, filamentli) olarak makroskobik ayrımı ve sayımı.
Raporlama: Toplam mantar sayısının baz alınarak mikrobiyolojik uygunluk değerlendirmesinin yapılması.
Neden Önemlidir?
Mantar kontaminasyonu, kozmetik sektöründe "sessiz tehlike" olarak bilinir:
Ürün Stabilitesi: Küfler, koruyucu sistemleri inaktive edebilir ve ürünün kimyasal yapısını bozabilir.
Tüketici Sağlığı: Bazı küf türleri tarafından üretilen mikotoksinler, deri üzerinde alerjik reaksiyonlara veya irritasyona neden olabilir.
Görsel Kalite: Ürün yüzeyinde görünen siyah veya yeşil noktalar (küf kolonileri), markanın imajına kalıcı zarar verir.
Uzmanlığınızı Lab Akademi ile Taçlandırın!
ISO 16212 kapsamındaki maya ve küf analizi, sabır ve yüksek dikkat gerektiren bir laboratuvar disiplinidir. Bu disiplini en iyi şekilde öğrenmenin yolu, uzman ellerden pratik eğitim almaktır.
Neden Bu Eğitimi Almalısınız? Kalite kontrol laboratuvarlarında sadece bakteri analizi bilmek yeterli değildir. Maya ve küf sayımı yapabilen uzmanlar, kozmetik sektöründe çok daha geniş bir istihdam alanına sahip olurlar.
Neden Lab Akademi’den Almalısınız?
Uygulamalı Öğrenme: Maltepe/İstanbul’daki eğitim merkezimizde mantar ekimlerini bizzat yapacak, 5 günlük gelişim süreçlerini ve koloni morfolojilerini deneyimli eğitmenlerimizle inceleyeceksiniz.
7 Sertifika Fırsatı: Bu eğitim paketinde ISO 16212 dahil tam 7 farklı uzmanlık sertifikası kazanarak CV'nizi parlatacaksınız.
Staj Şansı: Yüz yüze eğitime katılarak, çekilişle kazanacağınız Yaz Stajı ile sektörel ağınızı genişletme ve saha tecrübesi kazanma şansı yakalayacaksınız!
Kozmetik dünyasında güvenliğin koruyucusu olmak için bu profesyonel yolculuğa şimdi katılın.
👉 Eğitimi incelemek ve yerinizi ayırtmak için tıklayın: Kozmetik Mikrobiyolojisi Uzmanlık Eğitimi




